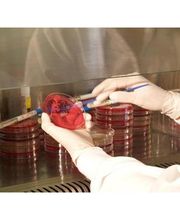
Gallery Cliente

Chiama ora!
Analisi Cliniche Gallieno
Ergoterapia · Ricerca
+39045918735 (Telefono)
+390458301190 (Fax)
Novità e Offerte
Info
Un valido laboratorio di analisi deve essere in grado di offrire ai propri utenti indagini diagnostiche accurate e complete, deve saper operare con discrezione e garantire la massima riservatezza, deve lavorare con serietà per trasformarsi in un vero e proprio punto d'appoggio fidato e credibile per tutti i suoi pazienti. Convenzione con SSN, il centro di Analisi Cliniche Gallieno di Verona è una struttura convenzionata con il Servizio Sanitario Nazionale, che possiede tutte queste caratteristiche. È un laboratorio moderno, dinamico, che utilizza strumentazioni di ultima generazione per offrire ai propri utenti: analisi cliniche; esami specialistici; analisi microbiologiche e tossicologiche; tutte eseguite scrupolose e rigorose. Esperienza e professionalità nel centro, aperto anche il sabato, operano medici specializzati e tecnici di laboratorio con una lunga, consolidata esperienza, preparati e costantemente aggiornati, ma anche dotati di grande sensibilità e capacità di ascolto. Spesso infatti chi si reca in un laboratorio di analisi cliniche per effettuare esami del sangue o delle urine non ha semplicemente bisogno di incontrare persone capaci, ma anche rassicuranti, in grado di confortare, tranquillizzare e mettere a proprio agio il paziente: proprio ciò che accade nel nostro laboratorio di Verona. Servizio analisi rapido, chi si reca al centro per un prelievo, tra le 7,30 e le 10 del mattino, ha inoltre la certezza di poter usufruire di un servizio particolarmente tempestivo. Infatti il laboratorio si è dotato di un sistema informatico innovativo che riduce enormemente i tempi di attesa per il paziente sia al momento dell'accettazione sia in quello del ritiro del referto.
Orari di apertura
- Lunedì
- 07:30 a 14:30
- Martedì
- 07:30 a 14:30
- Mercoledì
- 07:30 a 14:30
- Giovedì
- 07:30 a 14:30
- Venerdì
- 07:30 a 14:30
- Sabato
- Chiuso
- Domenica
- Chiuso
Galleria

Mappa
Via G. C. Abba, 12/A, 37126 Verona